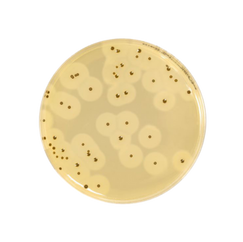

top of page
Reliable Microbiology Solutions for Food, Water & Environmental Safety
Biokar Diagnostic delivers high-quality French-engineered tools for microbiological testing. From culture media and reagents to molecular diagnostics, Biokar provides dependable solutions for food safety, water quality, and environmental monitoring. Trusted by laboratories worldwide, Biokar ensures precision, compliance, and reliable results across critical industries.
Need guidances? Reach out to us - we're here to help you to find the right Biokar solution for your testing needs.
Biokar Rapid Pathogenic Microbial Detection
bottom of page